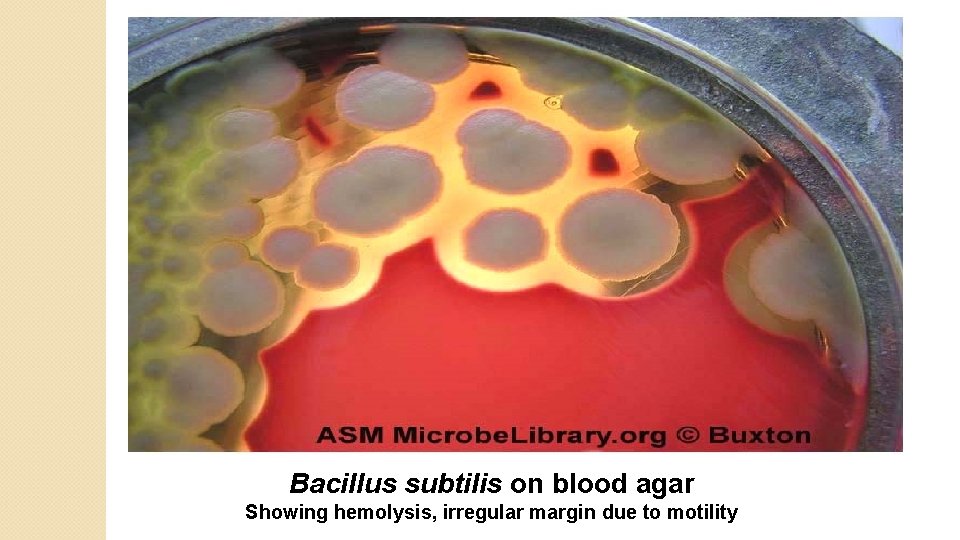
Bacillus subtilis on blood agar Showing hemolysis, irregular margin due to motility

Practical No 14 Genus Bacillus Genus Bacillus Pathogenic

Practical No. 14 Genus Bacillus

Genus Bacillus Pathogenic species Bacillus anthracis Saprophytic spp. Bacillus subtilis Animal reservoir Anthrax Bacillus cereus Dust, soil, water… Conjunctivitis Food poisoning

G+ve aerobic spore-forming bacilli: Two Bacillus species are considered medically significant: B. anthracis, which causes anthrax, and B. cereus, which causes a foodborne illness. A third species is B. subtilis, an important model organism. It is also a notable food spoiler; it is also one of the contaminants of culture media in bacteriology laboratories.

Bacillus anthracis: Bacillus anthracis is a Gram-positive spore-forming, rod-shaped bacterium. Bacillus anthracis spores in particular are highly resilient, surviving extremes of temperature, low-nutrient environments, and harsh chemical treatment over decades or centuries. It is the causative agent of anthrax. Three types of anthrax: 1. Cutaneous anthrax (malignant pustule). 2. Pulmonary anthrax (wool sorter's disease) and 3. Gastrointestinal anthrax.

Bacillus anthracis diseases: Cutaneous anthrax (95% of cases; malignant pustule (contact with infected animals or their products, spore, biting fly). Inhalation anthrax (4% of cases; Wool sorter's disease). (Inhalation of spore from the dust of wool, hair, or hides ) Gastrointestinal anthrax (rare).

Cutaneous Anthrax (Malignant pustule)

Laboratory diagnostic tests: Specimen: pus, sputum, stool. Smear: stained with gram's stain. Appears as large G +ve bacilli arranged singly, pairs or in chains with squared ends. In laboratory media, the bacilli form long chains. Spores develop at the end of the log phase of multiplication. These are central / subterminal, ellipsoidal and nonbulging and resist Gram stain, appearing as unstained areas within the cell. With malachite green/safranine (or malachite green/ basic fuchsin) staining, the spores are stained green and the vegetative forms are pink. In the Ziehl-Neelsen staining, spores are pink and the vegetative forms are blue. Capsules are lost in normal culture, the capsule is only seen if the specimen is taken from animal's exudates or from blood, by using a Mcfadyean reaction, capsule appears reddish purple and the bacillus appear blue. Mcfadyean reaction involves staining with polychrome methylene blue.

Specimens: Cutaneous anthrax Fluid (aspirate) or pus from lesion. Inhalation anthrax Sputum. Staining: -Gram stain: G + ve bacilli, cutted ends, arrange in chains, colorless spore. -Capsular staining: bacillus surrounded by halo (capsule). Capsular staining for Bacillus anthracis

Microscopical Characteristics G +ve, bacilli Cutted ends Arranged either single, pairs but mainly in chains bulging spore

Gram’s stain for Bacillus subtilis (short chains)

Culture: on blood agar and under aerobic conditions colonies appear white, granular, circular disks which have margins resembling a lock of hairs (the medusa head). Biochemical reactions: gelatin liquification ; Bacillus anthracis gives a positive result.

Macroscopical Characteristics: Aerobic. Haemolysis Species Haemolysis on blood agar Bacillus anthracis ـ ve Saprophytic spp. +ve Bacillus anthracis gray medusa head (under low power microscope), ground glass (frosted glass) appearance Saprophytic spp. circular with irregular margins Non – motile Bacillus anthracis Motile Saprophytic spp.
Bacillus subtilis on blood agar Showing hemolysis, irregular margin due to motility

Gelatin liquefaction (A) Negative. (B & C) positive

Differential characteristics of B. anthracis and nonpathogenic B. species No. Characters B. anthracis Non-pathogenic Bacillus spp. 1. Capsule Present (in clinical specimens) Absent 2. Motility Negative Positive 3. Haemolysis on Blood Agar Non-haemolytic ß haemolytic 4. Gelatin liquefaction Slow Rapid 5. Susceptibility to penicillin Susceptible Resistant 6. Animal pathogenicity Pathogenic (causes anthrax) Generally non-pathogenic

Serological tests: Ascoli precipitin test; is used for recognition of anthrax infection. About 2 grams of tissue is boiled for 5 minutes with 5 ml normal saline to which acetic acid has been added. The fluid is filtered, 0. 5 ml of anthrax antiserum is placed in a narrow tube and clear filtrate is carefully layered on the top of the serum. The development of a white ring of precipitate at the junction of the two fluids within 10 minutes at room temperature, denote positive results.


Serological Tests ELISA, IFA monoclonal antibodies against bacteria or exotoxin PCR Ascoli’s thermo-precipitatin : ring precipitation test to demonstrate anthrax Ag in tissue extract. Antibiotic sensitivity: ØBacillus anthracis is SENSITIVE to penicillin. Øsaprophytic spp. are RESISTANT to it. MAINLY USED NOW

Practical Genus Clostridium

Genus Clostridia G + ve Bacilli Anaerobic spore forming

Genus Clostridia They can cause disease when Suitable condition is present like anaerobic Tissue ischemia as in diabetes

Microscopical characteristics: * G + ve, large bacilli with blunted ends. * Spore forming: terminal or sub-terminal. Spore diameter is larger than bacilli diameter (projecting spore): C. tetani Terminal spore (Drum stick, diagnostic) C. botulinum Sub- terminal spore. (diagnostic)

Mode of transmission: Endo- / Exogenous(spore) Clostridia spp. C. Tetani C. botulinum C. perfringens (welchii) C. difficile Natural habitat Disease Virulence factors soil, dust (1 -25%) as transient bacteria in human Spastic paralysis (Tetanus), Neurotoxin toxigenic not invasive soil, dust Flaccid paralysis (Botulism) Neurotoxin (toxigenic not invasive) soil, dust, N. F of GIT, ♀ genital Gas gangrene (myonecrosis), tract anaerobic cellulitis endometritis Food poisoning Toxigenic and invasive (destraction host cell mem. ) Collagenase, protease, N. F of GIT Toxigenic not invasive (enterotoxin) AAD PMC Lecithinase (toxin α), haemolysin, leuckocidin, enterotoxin

Tetanus cases

Clostridium is G+ve, obligate anaerobic spore-forming bacilli. . Four main species responsible for disease in humans: Clostridium Gram perfrigens: +ve, non-motile, obligate anaerobe, spore-forming, capsulated in tissues or young cultures, rounded end bacilli. Spores The are oval, central or subterminal, not bulging. strains that produce more spores produce less toxins, and vice versa. Grow best on media containing carbohydrates such as; glucose agar, or glucose blood agar.

Spores of type A ( of types A-F) resist boiling for few minutes, while strains of food poisoning resist boiling for 1 -3 hours. Other strains can resist boiling for several hours. Produce narrow zone of complete hemolysis (theta toxin), while α- toxin produce a wide zone of hemolysis. Direct smear from deeper parts of the wound may show 3 types of Clostridia: 1 - C. perfringens; thick Gram +ve bacilli 2 - C. septicum; citron bodies, boat-shape, pleomorphic, with irregular staining. 3 - C. novyi; Large bacilli, with oval subterminal spores.

Clostridium tetani; Straight, slender, rod-shaped, rounded ends, curved or filamentous. Motile with peritrichous flagella Spores are rounded or oval terminal, form drum-stick appearance. Spores are highly resistant, may remain alive for years, and resist boiling for 15 -90 min. , some may resist dry heat at 1500 C for 1 hour.

Clostridium botulinum: Rod-shaped, single or in pairs or in chains Spores are oval, subterminal, bulging Spores formed best in sugar-free medium. Motile with 4 -8 peritrichous flagella Form large irregular, glistening colonies with fimbriated border. Meat is digested in cooked meat medium with putrid odour. Spores are destroyed at 180 o. C, and in dry heat for 5 -15 min. , and in boiling for 5 hours.


The fourth species is C. difficile which overgrows during antibiotic therapy, also may lead to pseudomembrane colitis. Clostridium 1. spp. could be divided into; Saccharolytic organisms; C. perfringens, ferments carbohydrates, produces acid and gas 2. Proteolytic organisms; C. tetani, digest proteins with blackening and bad smell production. 3. Mixed saccharolytic & proteolytic; certain groups of C. botulinum.

Laboratory diagnostic tests: Specimen: 1. Gram stain. 2. Culture: I. Wound, food, stool. Cultures are incubated under anaerobic conditions. Blood agar: most clostridia produce flat, gray, spreading colonies somewhat resembling those of Bacillus sp. They are also usually hemolytic. Clostridium perfringens produces raised, entire colonies with double zone hemolysis, the complete zone round the colony is due to theta toxin, and the wider zone around it is due to alpha toxin.

NOTE : C. Perfringens produce double zone of haemolysis.

Micro & Macroscopic C. perfringens NOTE: Large rectangular positive bacilli gram- NOTE: Double zone of hemolysis Inner beta-hemolysis = θ toxin Outer alphahemolysis = α toxin

II. Robertson's medium (cooked meat medium): Cooked Meat Medium provides a favorable environment for the growth of anaerobes, since the muscle protein in the heart tissue granules is a source of amino acids and other nutrients. The muscle tissue also provides reducing substances, particularly glutathione, which permits the growth of strict anaerobes. The sulfhydryl groups, which exert the reducing effect, are more available in denatured protein; therefore, the meat particles are cooked for use in the medium. Cooked Meat Medium is still widely used for the cultivation and maintenance of clostridia and for determining proteolytic activity of anaerobes. On Robertson's cooked meat medium → blackening of meat will be observed with the production of H 2 S and NH 3 (in the case of C. tetani).

The anaerobic conditions can be provided by: Anaerobic jar with gas pak Candle jar

The anaerobic conditions can be provided by: (Growth & gas produced are evident). Gas produced lifted the cooked meat particles to the surface. gas Chopped Meat Medium Tubes

III. Brewer Thioglycollate Medium : contains highly nutritious proteose peptone and beef infusion which support the growth of fastidious bacteria. Sodium thioglycollate helps to create anaerobic conditions. Methylene blue indicates oxygen content of the medium by exhibiting a bluish-green color of the medium in the presence of oxygen. Brewer's anaerobic jar is used for growing bacteria under anaerobic condition.

3. Biochemical tests: stormy fermentation In anaerobically-grown Litmus Milk cultures, enzymes of C. perfringens will attack the proteins and carbohydrates of the milk producing a "stormy fermentation" with acid production (the indicator, litmus turns pink), clotting of milk proteins, and gas formation.

4. Biochemical test Litmus milk (clot turns by gas) or called stormy fermentation, is a definitive diagnostic test for C. perfringens. Stormy fer. : Acid, gas, curd (clot) Stormy ferm. Acid / Gas / Curd

4. Serology test: Nagler's reaction for the detection of lecithinase activity: A test for the identification of alpha toxin of Clostridium perfringens; the addition of antitoxin to cultures on egg yolk agar prevents visible opacity, due to lecithinase action which is normally observed around colonies. An egg-yolk plate is divided into two halves. Over one half is spread with a specific antitoxin. The culture to be tested, together with a positive control is streaked across the plate, going from the untreated area of the plate to the area that is covered with antitoxin. The culture is then incubated anaerobically. Following incubation, lecithinase activity, caused by the action of the Clostridium perfringens a-toxin is seen as a precipitate in the medium on the side of the plate that did not receive the antitoxin, but not on the side that was treated.

C. perfringens Nagler Reaction NOTE: Lecithinase (α-toxin; phospholipase) hydrolyzes phospholipids in eggyolk agar around streak on right. Antibody against α-toxin inhibits activity around left streak.

Thank You
- Slides: 42